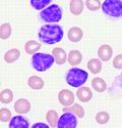

Відпустка для мами
Бути мамою - дуже складна цілодобова робота, яка зазвичай не винагороджується вихідними. Добре, якщо у вас є помічники, але, на жаль, сучасні бабусі не поспішають сісти вдома з онуками
далі...
Ігри для дітей, поробки, аплікації, орігамі, розмальовки, рецепти.
Бути мамою - дуже складна цілодобова робота, яка зазвичай не винагороджується вихідними. Добре, якщо у вас є помічники, але, на жаль, сучасні бабусі не поспішають сісти вдома з онуками
далі...
 |
Варимо суп? Або компот? Аплікація для самих маленьких дітей. |
 Ми всі любимо свій будинок. Тому, займаючись, оформлення і облаштуванням квартири, ми робимо це з особливою любов'ю і турботою. Особливо, коли це стосується дитячої кімнати.
Ми всі любимо свій будинок. Тому, займаючись, оформлення і облаштуванням квартири, ми робимо це з особливою любов'ю і турботою. Особливо, коли це стосується дитячої кімнати.
далі...
Найбільш зручна і універсальна одяг для юних футболістів і автогонщиків - це звичайно ж футболка. В ній можна і піти в садок, і в футбол поженуть і навіть під піджак одягнути на яку-небудь світсько-дитячу вечірку.
далі...
Прибирання в квартирі потрібно починати так : спочатку, треба витягнути з шафи речі які там зберігаються, і привести їх у порядок.
Прибирання в квартирі потрібно починати так : спочатку, треба витягнути з шафи речі які там зберігаються, і привести їх у порядок.
далі...
 Прибирання в квартирі потрібно починати так : спочатку, треба витягнути з шафи речі які там зберігаються, і привести їх у порядок.
Прибирання в квартирі потрібно починати так : спочатку, треба витягнути з шафи речі які там зберігаються, і привести їх у порядок.
далі...
День закоханих для багатьох є найщасливішим романтичним святом. Адже саме в цей день закохані вітають один одного, зізнаються в коханні, і отримують від цього масу приємних вражень.
далі...
Інтернет давно перестав бути чимось незвичайним. Сьогодні це місце роботи мільйонів людей і одночасно швидка інформація практично на будь-яку тему.
далі...
В останні роки кількість жінок, які в перший раз стають мамою після 35 років, помітно зростає. Так само перестали бути рідкістю перші пологи у 40 років. Чи говорить це про кризу? Пора починати турбуватися?
далі...
 Існує тільки одне слово, яке приблизно однаково звучить на всіх мовах світу, - це мама. Саме її бачить малюк, який зовсім недавно з'явився на світ, під пісні у виконанні яка подарувала йому життя, жінки, малюк засинає.
Існує тільки одне слово, яке приблизно однаково звучить на всіх мовах світу, - це мама. Саме її бачить малюк, який зовсім недавно з'явився на світ, під пісні у виконанні яка подарувала йому життя, жінки, малюк засинає.
далі...